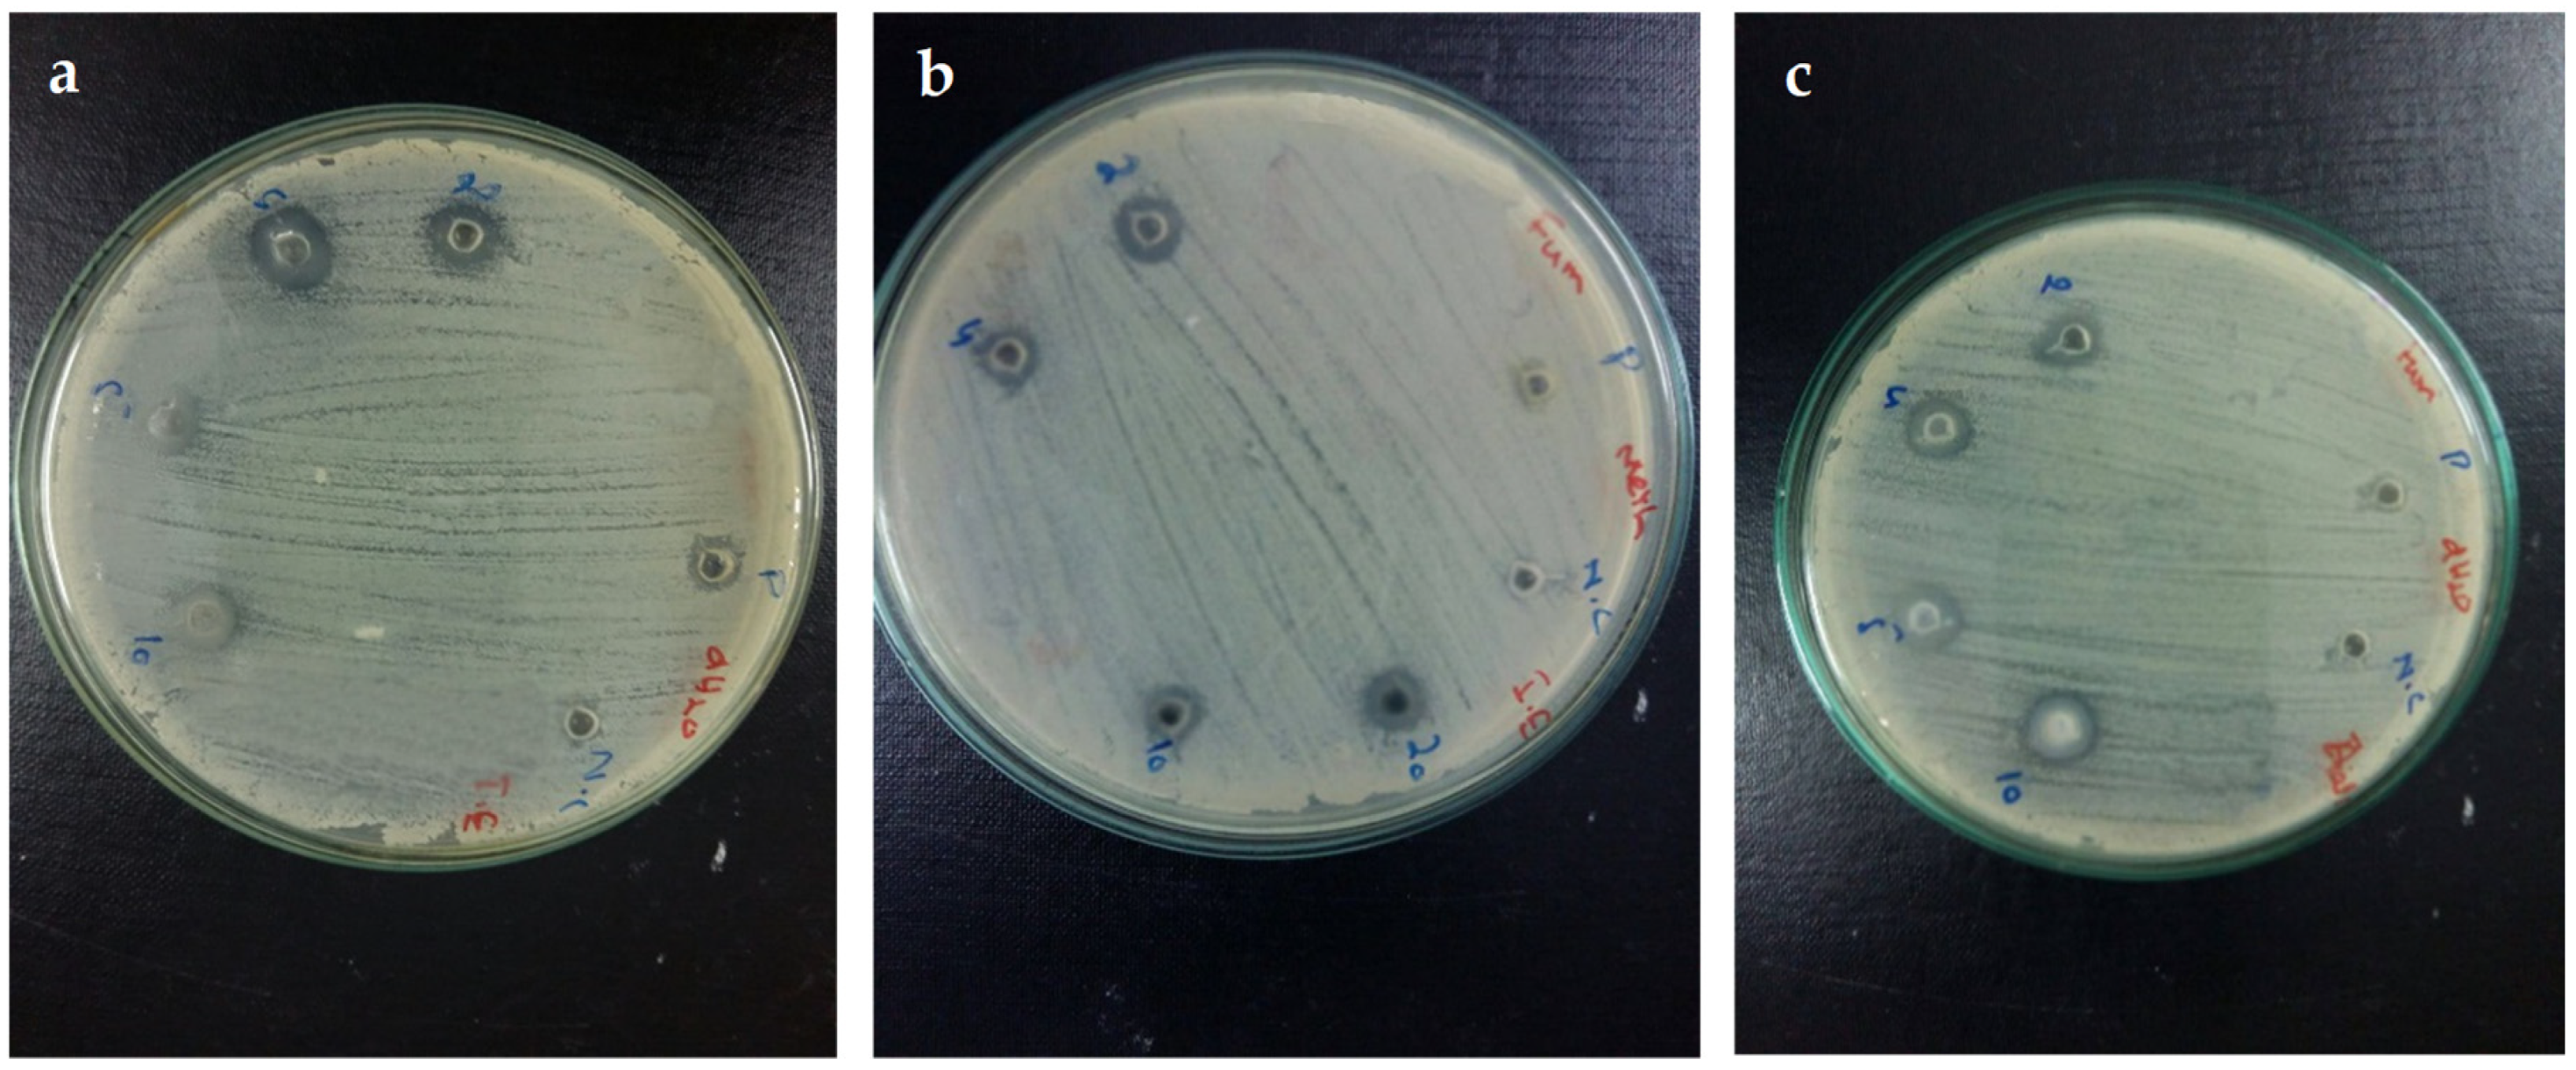

Green Bio-Assisted Synthesis, Characterization and Biological Evaluation of Biocompatible ZnO NPs Synthesized from Different Tissues of Milk Thistle (Silybum marianum)
Abstract
1. Introduction
2. Materials and Methods
2.1. Seeds Collection
2.2. Reagents
2.3. Preparation of Plant Extract
2.4. ZnO NPs Biosynthesis
2.5. Characterization
2.6. MTT Assay
2.6.1. Cell Culture
2.6.2. Evaluation of Mitochondrial Function using Cytotoxicity Analysis: MTT Assay
2.7. Antibacterial Potency
2.8. Total Antioxidant Capacity (TAC)
2.9. Total Reducing Power (TRP)
2.10. Free Radical Scavenging Assay (FRSA)
2.11. α-Amylase Inhibition Assay
2.12. Brine Shrimp Lethality Assay
2.13. Compatibility with Isolated Human Red Blood Cells (hRBCs)
controlAbs]. × 100
2.14. Statistical Analysis
3. Results
3.1. XRD Analysis
3.2. Scanning Electron Microscopy
3.3. FT-IR Analysis
3.4. Thermogravimetric Analysis (TGA)
3.5. Antibacterial Activities
3.6. Antioxidant In Vitro Capacities
3.7. α-Amylase In Vitro Inhibition Potential
3.8. Antiproliferative/Cytotoxic Activity against HepG2 Cancer Cells
3.9. Brine Shrimp Lethality Assay
3.10. Compatibility with Human Red Blood Cells (hRBCs)
4. Discussion
5. Conclusions
Author Contributions
Funding
Acknowledgments
Conflicts of Interest
References
- Mazzola, L. Commercializing nanotechnology. Nat. Biotech. 2003, 21, 1137–1143. [Google Scholar] [CrossRef] [PubMed]
- Wali, M.; Khan, M.A.; Nazir, M.; Siddiquah, A.; Mushtaq, S.; Hashmi, S.S.; Abbasi, B.H. Papaver Somniferum L. mediated novel bioinspired Lead Oxide (Pbo) and Iron Oxide (Fe2O3) nanoparticles: In-vitro biological applications, biocompatibility and their potential towards HEPG2 cell line. Mater. Sci. Eng. C 2019, 103, 109740. [Google Scholar]
- Thakkar, K.N.; Mhatre, S.S.; Parikh, R.Y. Biological synthesis of metallic nanoparticles. Nanomedicine 2010, 6, 257–262. [Google Scholar] [CrossRef] [PubMed]
- Kulkarni, N.; Muddapur, U. Biosynthesis of metal nanoparticles: A review. J. Nanotech. 2014, 2014, 510246. [Google Scholar] [CrossRef]
- Abdel-Hameed, E.S.S. Total phenolic contents and free radical scavenging activity of certain Egyptian Ficus species leaf samples. Food Chem. 2009, 114, 1271–1277. [Google Scholar] [CrossRef]
- Mukherjee, P.; Ahmad, A.; Mandal, D.; Senapati, S.; Sainkar, R.S.; Khan, M.I.; Parishcha, R.; Ajaykumar, P.V.; Alam, M.; Kumar, R.; et al. Fungus-mediated synthesis of silver nanoparticles and their immobilization in the mycelial matrix: A novel biological approach to nanoparticle synthesis. Nano Lett. 2001, 1, 515–519. [Google Scholar] [CrossRef]
- Manuela, S.; Adriana, P.; Toloman, D.; Adriana, D.; Lung, I.; Katona, G. Enhanced photocatalytic degradation properties of Zinc Oxide nanoparticles synthesized by using plant extracts. Mater. Sci. Semicond. Proc. 2015, 39, 23–29. [Google Scholar]
- Mittal, A.K.; Chisti, Y.; Banerjee, Y.C. Synthesis of metallic nanoparticles using plant extracts. Biotechnol. Adv. 2013, 31, 346–356. [Google Scholar] [CrossRef] [PubMed]
- Sangeetha, G.; Rajeshwari, S.; Venckatesh, R. Green synthesis of Zinc Oxide nanoparticles by Aloe barbadensis Miller leaf extract: Structure and optical properties. Mater. Res. Bull. 2011, 46, 2560–2566. [Google Scholar] [CrossRef]
- Sharma, D.; Sharma, S.; Kaith, B.S.; Rajput, J.; Kaur, M. Synthesis of ZnO nanoparticles using surfactant free in-air and microwave method. Appl. Surf. Sci. 2011, 257, 9661–9672. [Google Scholar] [CrossRef]
- Chen, C.H.; Chang, S.J.; Chang, S.P.; Li, M.J.; Chen, I.C.; Hsueh, T.J.; Hsu, A.D.; Hsu, C.L. Fabrication of a white-light-emitting diode by doping gallium into ZnO nanowire on a P-gan substrate. J. Phys. Chem. C 2010, 114, 12422–12426. [Google Scholar] [CrossRef]
- Hsu, C.L.; Chen, K.C. Improving piezoelectric nanogenerator comprises ZnO nanowires by bending the flexible pet substrate at low vibration frequency. J. Phys. Chem. C. 2012, 116, 9351–9355. [Google Scholar] [CrossRef]
- Gao, PX.; Ding, Y.; Wang, Z.L. Crystallographic orientation-aligned ZnO nanorods grown by a tin catalyst. Nano Lett. 2003, 3, 1315–1320. [Google Scholar] [CrossRef]
- Hu, Y.; Zhang, Y.; Chang, Y.; Snyder, R.L.; Wang, Z.L. Optimizing the power output of a ZnO photocell by piezopotential. ACS Nano 2010, 4, 4220–4224. [Google Scholar] [CrossRef] [PubMed]
- Yang, J.L.; An, S.J.; Park, W.I.; Yi, G.C.; Choi, W. Photocatalysis using ZnO thin films and nanoneedles grown by metal–organic chemical vapor deposition. Adv. Mater. 2004, 16, 1661–1664. [Google Scholar] [CrossRef]
- Hsueh, T.J.; Hsu, C.L. Fabrication of gas sensing devices with ZnO nanostructure by the low-temperature oxidation of zinc particles. Sens. Actuat. B Chem. 2008, 131, 572–576. [Google Scholar] [CrossRef]
- Meulenkamp, E.A. Synthesis and growth of ZnO nanoparticles. J. Phys. Chem. 1998, 102, 5566–5572. [Google Scholar] [CrossRef]
- Baxter, J.B.; Walker, A.M.; Ommering, K.V.; Aydil, A.S. Synthesis and characterization of ZnO nanowires and their integration into dye-sensitized solar cells. Nanotechnology 2006, 17, S304. [Google Scholar] [CrossRef]
- Sheng, Y.; Adiga, N.; Ba, S.; Dasgupta, T.; Wu, C.F.J.; Wang, Z.L. Optimizing and improving the growth quality of ZnO nanowire arrays guided by statistical design of experiments. ACS Nano 2009, 3, 1803–1812. [Google Scholar]
- Jiang, C.Y.; Sun, X.W.; Lo, G.Q.; Kwong, D.L.; Wang, J.X. Improved dye-sensitized solar cells with a ZnO-nanoflower photoanode. Appl. Phys. Lett. 2007, 90, 263501. [Google Scholar] [CrossRef]
- Paithankar, V.V.; Raut, K.K.; Charde, R.M.; Vyas, J.V. Phyllanthus Niruri: A magic herb. Res. Pharm. 2011, 1, 1–9. [Google Scholar]
- Senthilraja, A.; Subash, B.; Rajamanickam, K.D.; Swaminathan, M.; Shanthi, M. Synthesis, characterization and catalytic activity of co-doped Ag–Au–ZnO for MB dye degradation under UV-A light. Mater. Sci. Semicond. Proc. 2014, 22, 83–91. [Google Scholar] [CrossRef]
- Madhumitha, G.; Rajakumar, G.; Roopan, S.M.; Rahuman, A.A.; Priya, K.M.; Saral, A.M.; Khan, F.R.N.; Khanna, V.G.; Velayutham, K.; Jayaseelan, C. Acaricidal, insecticidal and larvicidal efficacy of fruit peel aqueous extract of Annona squamosa and its compounds against blood-feeding parasites. Parasit. Res. 2012, 111, 2189–2199. [Google Scholar] [CrossRef] [PubMed]
- Madhumitha, G.; Saral, A.M. Free radical scavenging assay of Thevetia neriifolia leaf extracts. Asian J. Chem. 2009, 21, 2468–2470. [Google Scholar]
- Jafarirad, S.; Ardehjani, P.H.; Movafeghi, A. Are the green synthesized nanoparticles safe for environment? A case study of aquatic plant Azolla filiculoides as an indicator exposed to magnetite nanoparticles fabricated using microwave hydrothermal treatment and plant extract. J. Environ. Sci. Health A 2010, 54, 516–527. [Google Scholar] [CrossRef]
- Mohanpuria, P.; Rana, N.K.; Yadav, S.K. Biosynthesis of nanoparticles: Technological concepts and future applications. J. Nanopart. Res. 2008, 10, 507–517. [Google Scholar] [CrossRef]
- Khan, M.; Al-Marri, A.H.; Khan, M.; Shaik, M.R.; Mohri, N.; Adil, S.F.; Kuniyil, M.; Alkhathlan, H.Z.; Al-Warthan, A.; Tremel, T.; et al. Green approach for the effective reduction of graphene oxide using Salvadora persica L. root (miswak) extract. Nanoscale Res. Lett. 2015, 10, 281. [Google Scholar] [CrossRef]
- Ochiai, S.; Kumar, P.; Santhakumar, K.; Shin, P.K. Examining the effect of additives and thicknesses of hole transport layer for efficient organic solar cell devices. Electron. Mater. Lett. 2013, 9, 399–403. [Google Scholar] [CrossRef]
- Kumar, P.; Santhakumar, K.; Tatsugi, J.; Shin, P.-K.; Ochiai, S. Comparison of properties of polymer organic solar cells prepared using highly conductive modified pedot Pss films by spin-and spray-coating methods. Jpn. J. Appl. Phys. 2013, 53, 01AB08. [Google Scholar] [CrossRef]
- Saitoh, L.; Babu, R.R.; Kannappan, S.; Kojima, K.; Mizutani, T.; Ochiai, S. Performance of spray deposited poly [N-9″-hepta-decanyl-2,7-carbazole-alt-5,5-(4′,7′-di-2-thienyl-2′,1′,3′-benzothiadiazole)] [6,6]-phenyl-C61-butyric acid methyl ester blend active layer based bulk heterojunction organic solar cell devices. Thin Solid Films. 2012, 520, 3111–3117. [Google Scholar] [CrossRef]
- Gunalan, S.; Sivaraj, R.; Rajendran, V. Green synthesized ZnO nanoparticles against bacterial and fungal pathogens. Prog. Nat. Sci. Mater. Int. 2012, 22, 693–700. [Google Scholar] [CrossRef]
- Özgür, Ü.; Alivov, Y.I.; Liu, C.; Teke, A.; Reshchikov, M.A.; Doğan, S.; Avrutin, V.; Cho, S.J.; Morkoç, H. A comprehensive review of ZnO materials and devices. J. Appl. Phys. 2005, 98, 041301. [Google Scholar] [CrossRef]
- Djurišić, A.; Chen, B.; Leung, X.; Ng, Y.H. ZnO nanostructures: Growth, properties and applications. J. Mater. Chem. 2012, 22, 6526–6535. [Google Scholar] [CrossRef]
- Wang, Z.L. Zinc oxide nanostructures: Growth, properties and applications. J. Phys. Cond. Matt. 2004, 16, R829. [Google Scholar] [CrossRef]
- Ali, K.; Dwivedi, S.; Azam, A.; Saquib, Q.; Al-Said, M.S.; Alkhedhairy, A.A.; Musarrat, J. Aloe vera extract functionalized zinc oxide nanoparticles as nanoantibiotics against multi-drug resistant clinical bacterial isolates. J. Colloid. Interface Sci. 2016, 15, 145–156. [Google Scholar] [CrossRef] [PubMed]
- Gnanasangeetha, D.; SaralaThambavani, D. One pot synthesis of zinc oxide nanoparticles via chemical and green method. Res. J. Mater. Sci. 2013, 1, 1–8. [Google Scholar]
- Samat, N.A.; Nor, R.M. Sol–gel synthesis of zinc oxide nanoparticles using Citrus aurantifolia extracts. Ceram. Int. 2013, 39, S545–S548. [Google Scholar] [CrossRef]
- Singh, R.P.; Shukla, V.K.; Yadav, R.S.; Sharma, P.K.; Singh, P.K.; Pandey, A.C. Biological approach of zinc oxide nanoparticles formation and its characterization. Adv. Mater. Lett. 2011, 2, 313–317. [Google Scholar] [CrossRef]
- Rajiv, P.; Rajeshwari, S.; Venckatesh, R. Bio-fabrication of zinc oxide nanoparticles using leaf extract of Parthenium hysterophorus L. and its size-dependent antifungal activity against plant fungal pathogens. Spectrochim. Acta A Mol. Biomol. Spectrosc. 2013, 112, 384–387. [Google Scholar] [CrossRef]
- Beato, V.M.; Orgaz, F.; Mansilla, F.; Montaño, A. Changes in phenolic compounds in garlic (Allium sativum L.) owing to the cultivar and location of growth. Plant Food. Hum. Nutr. 2011, 66, 218–223. [Google Scholar] [CrossRef]
- Fatima, H.; Khan, K.; Zia, M.; Ur-Rehman, T.; Mirza, B.; Haq, I.U. Extraction optimization of medicinally important metabolites from Datura innoxia Mill.: An in vitro biological and phytochemical investigation. BMC Complement. Altern. Med. 2015, 19, 376. [Google Scholar] [CrossRef] [PubMed]
- Ahmed, M.; Fatima, H.; Qasim, M.; Gul, B.; Haq, IU. Polarity directed optimization of phytochemical and in vitro biological potential of an indigenous folklore: Quercus dilatata Lindl. ex Royle. BMC Complement. Altern. Med. 2017, 17, 386. [Google Scholar] [CrossRef] [PubMed]
- Zahra, S.S.; Ahmed, M.; Qasim, M.; Gul, B.; Zia, M.; Mirza, B.; Haq, I.U. Polarity based characterization of biologically active extracts of Ajuga bracteosa Wall. ex Benth. and Rp-HPLC analysis. BMC Complement. Altern. Med. 2017, 17, 443. [Google Scholar] [CrossRef] [PubMed]
- Tomankova, K.; Polakova, K.; Pizova, K.; Binder, S.; Havrdova, M.; Kolarova, M.; Kriegova, E.; Zapletalova, J.; Malina, L.; Horakova, J. In vitro cytotoxicity analysis of doxorubicin-loaded/superparamagnetic iron oxide colloidal nanoassemblies on MCF7 and NIH3T3 cell lines. Int. J. Nanomed. 2015, 29, 949–961. [Google Scholar] [CrossRef] [PubMed]
- Khalil, A.T.; Ovais, M.; Ullah, I.; Ali, M.; Shinwari, ZK.; Khamlich, S.; Maaza, M. Sageretia thea (osbeck.) mediated synthesis of zinc oxide nanoparticles and its biological applications. Nanomedicine 2017, 12, 1767–1789. [Google Scholar] [CrossRef] [PubMed]
- Saraswathi, V.S.; Tatsugi, J.; Shin, P.K.; Santhakumar, K. Facile biosynthesis, characterization, and solar assisted photocatalytic effect of ZnO nanoparticles mediated by leaves of L. Speciosa. J. Photochem. Photobiol. B Biol. 2017, 167, 89–98. [Google Scholar] [CrossRef] [PubMed]
- Bhuyan, T.; Mishra, K.; Khanuja, M.; Prasad, R.; Varma, A. Biosynthesis of zinc oxide nanoparticles from Azadirachta indica for antibacterial and photocatalytic applications. Mater. Sci. Semicond Process 2015, 32, 55–61. [Google Scholar] [CrossRef]
- Dobrucka, R.; Długaszewska, J. Biosynthesis and antibacterial activity of ZnO nanoparticles using Trifolium pratense flower extract. Saudi J. Biol. Sci. 2016, 23, 517–523. [Google Scholar] [CrossRef]
- Elumalai, K.; Velmurugan, S. Green synthesis, characterization and antimicrobial activities of zinc oxide nanoparticles from the leaf extract of Azadirachta indica (L.). Appl. Surf. Sci. 2015, 345, 329–336. [Google Scholar] [CrossRef]
- Siddiqi, K.S.; Ur Rahman, A.; Husen, A. Properties of zinc oxide nanoparticles and their activity against microbes. Nanoscale Res. Lett. 2018, 13, 141. [Google Scholar] [CrossRef]
- Sirelkhatim, A.; Mahmud, S.; Seeni, A.; Kaus, N.H.M.; Ann, L.C.; Bakhori, S.K.M.; Hasan, H.; Mohamad, D. Review on zinc oxide nanoparticles: Antibacterial activity and toxicity mechanism. Nano-Micro Lett. 2015, 7, 219–242. [Google Scholar] [CrossRef] [PubMed]
- Ul-Haq, I.; Ullah, N.; Bibi, G.; Kanwal, S.; Ahmad, M.S.; Mirza, B. Antioxidant and cytotoxic activities and phytochemical analysis of Euphorbia wallichii root extract and its fractions. Iran. J. Pharm. Res. 2012, 11, 241. [Google Scholar]
- Smuleac, V.; Varma, R.; Sikdar, S.; Bhattacharyya, D. Green synthesis of Fe and Fe/Pd bimetallic nanoparticles in membranes for reductive degradation of chlorinated organics. J. Memb. Sci. 2011, 379, 131–137. [Google Scholar] [CrossRef] [PubMed]
- Ahmed, D.; Younas, S.; Anwer-Mughal, Q.M. Study of alpha-amylase and urease inhibitory activities of Melilotus indicus (Linn.) All. Pak. J. Pharm. Sci. 2014, 27, 57–61. [Google Scholar]
- Aula, S.; Lakkireddy, S.; Swamy, A.V.N.; Kapley, A.; Jamil, K.; Tata, N.R.; Hembram, K. Biological interactions in vitro of zinc oxide nanoparticles of different characteristics. Mater. Res. Exp. 2014, 1, 035041. [Google Scholar] [CrossRef]
- Ali, S.S.; Morsy, R.; El-Zawawy, N.A.; Fareed, M.F.; Bedaiwy, M.Y. Synthesized zinc peroxide nanoparticles (ZnO2-NPs): A novel antimicrobial, anti-elastase, anti-keratinase, and anti-inflammatory approach toward polymicrobial burn wounds. Int. J. Nanomed. 2017, 12, 6059. [Google Scholar] [CrossRef]
- Zak, A.K.; Abd Majid, W.H.; Abrishami, M.E.; Yousefi, R. X-ray analysis of ZnO nanoparticles by williamson–hall and size–strain plot methods. Solid State Sci. 2011, 13, 251–256. [Google Scholar]
- Senthilkumar, S.R.; Sivakumar, T. Green tea (Camellia Sinensis) mediated synthesis of zinc oxide (ZnO) nanoparticles and studies on their antimicrobial activities. Int. J. Pharm. Pharm. Sci. 2014, 6, 461–465. [Google Scholar]
- Vidya, C.; Hiremath, S.; Chandraprabha, M.N.; Antonyraj, M.A.L.; Gopal, I.V.; Jain, A.; Bansal, K. Green synthesis of ZnO nanoparticles by Calotropis gigantea. Int. J. Curr. Eng. Technol. 2013, 1, 118–120. [Google Scholar]
- Drouet, S.; Abbasi, B.H.; Falguières, A.; Ahmad, W.; Ferroud, C.; Doussot, J.; Vanier, J.; Lainé, E.; Hano, C. Single laboratory validation of a quantitative core shell-based LC separation for the evaluation of silymarin. variability and associated antioxidant activity of pakistani ecotypes of milk thistle (Silybum marianum L.). Molecules 2018, 23, 904. [Google Scholar] [CrossRef]
- Matinise, N.; Fuku, X.G.; Kaviyarasu, K.; Mayedwa, N.; Maaza, M. ZnO nanoparticles via Moringa oleifera green synthesis: Physical properties & mechanism of formation. Appl. Surf. Sci. 2017, 406, 339–347. [Google Scholar]
- Nagajyothi, P.C.; An, M.T.N.; Sreekanth, T.V.M.; Lee, J.I.; Lee, D.J.; Lee, K.D. Green route biosynthesis: Characterization and catalytic activity of ZnO nanoparticles. Mater. Lett. 2013, 108, 160–163. [Google Scholar] [CrossRef]
- Hameed, S.; Khalil, A.T.; Ali, M.; Numan, M.; Khamlich, S.; Shinwari, Z.K.; Maaza, M. Greener synthesis of ZnO and Ag–ZnO nanoparticles using Silybum marianum for diverse biomedical applications. Nanomedicine 2019, 14, 655–673. [Google Scholar] [CrossRef] [PubMed]
- Prasad, C.; Sreenivasulu, K.; Gangadhara, S.; Venkateswarlu, P. Bio inspired green synthesis of Ni/Fe3O4 magnetic nanoparticles using Moringa oleifera leaves extract: A magnetically recoverable catalyst for organic dye degradation in aqueous solution. J. Alloy. Compd. 2017, 700, 252–258. [Google Scholar] [CrossRef]
- Jalal, R.; Goharshadi, E.K.; Abareshi, M.; Moosavi, M.; Yousefi, A.; Nancarrow, P. ZnO nanofluids: Green synthesis, characterization, and antibacterial activity. Mater. Chem. Phys. 2010, 121, 198–201. [Google Scholar] [CrossRef]
- Ramesh, M.; Anbuvannan, M.; Viruthagiri, G. Green synthesis of ZnO nanoparticles using Solanum nigrum leaf extract and their antibacterial activity. Spectrochim. Acta A Mol. Biomol. Spectrosc. 2015, 136, 864–870. [Google Scholar] [CrossRef]
- Suresh, D.; Nethravathi, P.C.; Rajanaika, H.; Nagabhushana, H.; Sharma, S.C. Green synthesis of multifunctional zinc oxide (ZnO) nanoparticles using Cassia fistula plant extract and their photodegradative, antioxidant and antibacterial activities. Mater. Sci. Semicond. Process. 2015, 31, 446–454. [Google Scholar] [CrossRef]
- Nagajyothi, P.C.; Cha, S.J.; Yang, I.J.; Sreekanth, T.V.M.; Kim, K.J.; Shin, H.M. Antioxidant and anti-inflammatory activities of zinc oxide nanoparticles synthesized using Polygala tenuifolia root extract. J. Photochem. Photobiol. B Biol. 2015, 146, 10–17. [Google Scholar] [CrossRef]
- Suresh, D.; Shobharani, R.M.; Nethravathi, P.C.; Pavan Kumar, M.A.; Nagabhushana, H.; Sharma, S.C. Artocarpus gomezianus aided green synthesis of ZnO nanoparticles: Luminescence, photocatalytic and antioxidant properties. Spectrochim. Acta A Mol. Biomol. Spectrosc. 2015, 136, 128–134. [Google Scholar] [CrossRef]
- Bala, N.; Saha, S.; Chakraborty, M.; Maiti, M.; Das, S.; Basu, R.; Nandy, P. Green synthesis of zinc oxide nanoparticles using Hibiscus subdariffa leaf extract: Effect of temperature on synthesis, anti-bacterial activity and anti-diabetic activity. RSC Adv. 2015, 5, 4993–5003. [Google Scholar] [CrossRef]
- Rajakumar, G.; Thiruvengadam, M.; Mydhili, G.; Gomathi, T.; Chung, I.M. Green approach for synthesis of zinc oxide nanoparticles from Andrographis paniculata leaf extract and evaluation of their antioxidant, anti-diabetic, and anti-inflammatory activities. Bioprocess Biosyst. Eng. 2018, 41, 21–30. [Google Scholar] [CrossRef] [PubMed]
- Nagajyothi, P.C.; Sreekanth, T.V.; Tettey, C.O.; Jun, Y.I.; Mook, S.H. Characterization, antibacterial, antioxidant, and cytotoxic activities of ZnO nanoparticles using Coptidis rhizoma. Bioorg. Med. Chem. Lett. 2014, 24, 4298–4303. [Google Scholar] [CrossRef] [PubMed]
- Vijayakumar, S.; Vaseeharan, B.; Malaikozhundan, B.; Shobiya, M. Laurus nobilis leaf extract mediated green synthesis of ZnO nanoparticles: Characterization and biomedical applications. Biomed. Pharmacother. 2016, 84, 1213–1222. [Google Scholar] [CrossRef] [PubMed]
- Prashanth, G.K.; Prashanth, P.A.; Bora, U.; Gadewar, M.; Nagabhushana, B.M.; Ananda, S.; Krishnaiah, G.M.; Sathyananda, H.M. In vitro antibacterial and cytotoxicity studies of ZnO nanopowders prepared by combustion assisted facile green synthesis. Karbala Int. J. Mod. Sci. 2015, 1, 67–77. [Google Scholar]

| Samples | S. aureus | B. subtilis | K. pneumonia | P. aeruginosa | E. coli | |||||
|---|---|---|---|---|---|---|---|---|---|---|
| C-ZNPs | 16.03 ± 0.58 ab | 33.33 | 7.48 ± 0.60 ab | − | 17.66 ± 1.11 a | ≥100 | 16.28 ± 0.33 a | ≥100 | 9.83 ± 0.47 a | − |
| S-ZNPs | 20.55 ± 0.98 a | ≥100 | 8.29 ± 0.58 a | − | 15.56 ± 0.93 ab | − | 13.88 ± 0.54 b | − | 7.06 ± 0.92 ab | − |
| W-ZNPs | 14.85 ± 1 b | 100 | 9.58 ± 0.60 a | − | 15.39 ± 0.86 ab | − | 15.53 ± 0.66 ab | − | 1.07 ± 0.75 a | − |
| P-ZNPs | 15.96 ± 0.88 b | ≥100 | 8.21 ± 0.97 a | − | 13.44 ± 0.79 b | ≥100 | 17.91 ± 0.78 a | ≥100 | 1.73 ± 0.48 | − |
| positive control | 13.74 ± 0.7 bc | 8.06 ± 0.7 a | 12.32 ± 0.9 b | 12.85 ± 78 b | 8.33 ± 0.7 ab | |||||
| negative control | 8.77 ± 0.6 cd | 6.65 ± 0.5 ab | 7.03 ± 0.6 c | 7.91 ± 0.5 c | 7.85 ± 0.6 ab | |||||
| Sample | % Viability (Mean ± SD) |
|---|---|
| NTC | 100.90 ± 5.30 c |
| W-ZNPs | 13.16 ± 1.83 a |
| C-ZNPs | 13.10 ± 2.83 a |
| S-ZNPs | 22.88 ± 1.58 ab |
| P-ZNPs | 20.12 ± 1.05 ab |
| Sample | % Mortality Rate (at 200 µg/mL NPs) | LC 50 (μg/mL) |
|---|---|---|
| C-ZNPs | 96.6 ± 0.6 a | 10.17 |
| S-ZNPs | 90 ± 0.6 b | 62.5 |
| W-ZNPs | 93.3 ± 0.6 ab | 38.46 |
| P-ZNPs | 96.6 ± 0.6 a | 21.06 |
© 2019 by the authors. Licensee MDPI, Basel, Switzerland. This article is an open access article distributed under the terms and conditions of the Creative Commons Attribution (CC BY) license (http://creativecommons.org/licenses/by/4.0/).
Share and Cite
Abbasi, B.H.; Shah, M.; Hashmi, S.S.; Nazir, M.; Naz, S.; Ahmad, W.; Khan, I.U.; Hano, C. Green Bio-Assisted Synthesis, Characterization and Biological Evaluation of Biocompatible ZnO NPs Synthesized from Different Tissues of Milk Thistle (Silybum marianum). Nanomaterials 2019, 9, 1171. https://doi.org/10.3390/nano9081171
Abbasi BH, Shah M, Hashmi SS, Nazir M, Naz S, Ahmad W, Khan IU, Hano C. Green Bio-Assisted Synthesis, Characterization and Biological Evaluation of Biocompatible ZnO NPs Synthesized from Different Tissues of Milk Thistle (Silybum marianum). Nanomaterials. 2019; 9(8):1171. https://doi.org/10.3390/nano9081171
Chicago/Turabian StyleAbbasi, Bilal Haider, Muzamil Shah, Syed Salman Hashmi, Munazza Nazir, Sania Naz, Waqar Ahmad, Inam Ullah Khan, and Christophe Hano. 2019. "Green Bio-Assisted Synthesis, Characterization and Biological Evaluation of Biocompatible ZnO NPs Synthesized from Different Tissues of Milk Thistle (Silybum marianum)" Nanomaterials 9, no. 8: 1171. https://doi.org/10.3390/nano9081171
APA StyleAbbasi, B. H., Shah, M., Hashmi, S. S., Nazir, M., Naz, S., Ahmad, W., Khan, I. U., & Hano, C. (2019). Green Bio-Assisted Synthesis, Characterization and Biological Evaluation of Biocompatible ZnO NPs Synthesized from Different Tissues of Milk Thistle (Silybum marianum). Nanomaterials, 9(8), 1171. https://doi.org/10.3390/nano9081171

